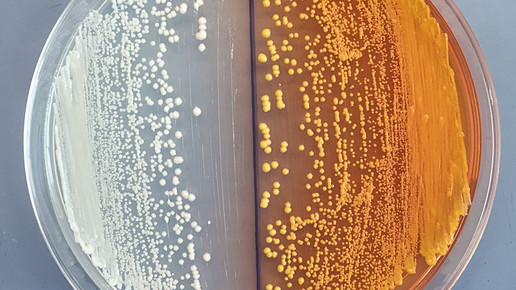
opiate William De Loache UC Berkeley

Ich will mein Geld zurück!
Margaret Thatcher hat es vorgemacht. Mit ihrem berühmten Satz „I want my money back“ setzte die Eiserne Lady 1984 den „Britenrabatt“ durch – und bis heute hat Großbritannien diesen Sonderstatus innerhalb der EU. Offiziell heißt der Rabatt für das damals etwas klamme Königreich übrigens VK-Ausgleich. Klingt irgendwie nach Großhandelsrechnung. Und was riefen die Großhändler in dieser Woche? „Wir wollen unser Geld zurück!“
Gemeint sind die AMNOG-Millionen: Bei den Apothekern holte sich die schwarz-gelbe Bundesregierung mit einem erhöhten Kassenabschlag tatsächlich 200 Millionen Euro ab. Die gleiche Summe sollten die Großhändler beisteuern, finanziert aus einer Honorarumstellung.
Der Wechsel auf eine Fixpauschale war zwar ein lang ersehnter Wunsch der Großhändler – er kam aber anders als erhofft, und die Grossisten jaulten auf. „Sonderopfer“, das klingt auch schon schrecklich. Früher opferten sich Helden oder Märtyrer und wurden dafür gefeiert und verehrt. Heute ist „Opfer“ nur noch ein Schimpfwort auf dem Schulhof. Und was ist dann erst ein „Sonderopfer“?
Wie viel ihres Sonderopfers die Großhändler tatsächlich selbst erduldeten oder welchen Anteil sie dem rudernden Nebenmann im gemeinsamen Boot überließen, dazu hat jeder Apotheker seine eigene Vorstellung. Heute zählt für den Großhandel vor allem der Fehler in der Rechnung: Man war mit der Politik davon ausgegangen, dass die Rx-Packungszahlen ambitionierter steigen würden, die neue Währung hätte sich dann ausgezahlt. So aber sehen die Großhändler nur eine Lücke klaffen und sprechen bei den Ministern Gröhe und Gabriel vor.
Zwar gilt im Gesundheitswesen ein Gesetz, dass der Topf immer nur anders verteilt wird, dennoch könnten auch die Apotheker von einer Honorarerhöhung der Großhändler profitieren. Da sind sie zumindest wirtschaftlich am nächsten dran und könnten darauf hoffen, dass der Wettbewerb ihnen etwas von ihrem Sonderopfer zurück in die geplünderten Kassen spült. Nötig wäre es, zumal sie selbst politisch zuletzt ja nicht so erfolgreich waren – aber das Thema hatten wir schon.
Wer darauf nicht mehr warten kann oder will, verkauft seine Apotheke. Und dabei muss mit einem Vorurteil aufgeräumt werden: Auf die Größe kommt es doch an. Durchschnittlich werden Apotheken nach Zahlen der Apobank zwar teurer verkauft: 61.000 Euro beziehungsweise 18 Prozent im Vergleich zu Vorjahreswerten. Aber: Apotheken mit einem Umsatz von 700.000 Euro möchte niemand, und dazu kann die Apobank auch nicht raten. Vor „kleinen Buden“ hatte schon ein Anderer gewarnt – aber das Thema hatten wir auch schon.
Und wer soll die Apotheken – und vor allem die Filialverbünde – auch kaufen, wenn es immer weniger junge Pharmazeuten in die Offizin zieht. Die Großhändler? Die wollen angeblich gar nicht, die mögen angeblich gar keine Apothekenketten. Meint jedenfalls Phagro-Chef Dr. Thomas Trümper. Und wenn sie sich im Ausland doch mal eine Kette zulegen, dann gewissermaßen aus Notwehr, weil sie den Markt sonst abschenken müssten. Das Phänomen, dass GLOBALE Großkonzerne immer erst dann in einen Markt einsteigen, wenn sie von kleinen nationalen Playern dazu gezwungen werden, ist in der Wirtschaftswissenschaft als Trümperism bekannt.
Ein Sträußchen hat der Phagro-Chef noch mit dem Großhändler AEP auszufechten. Es geht um das leidige Skonto-Thema. Der Newcomer steht deshalb vor Gericht, hat in seiner Klageerwiderung aber einen interessanten neuen Aspekt aufgetan: Weil alle Skonti gewährten, könne es gar keine Wettbewerbsverzerrung geben. Also hüte die Wettbewerbszentrale mit ihrer Klage gar nicht den Wettbewerb, also sei die Klage missbräuchlich. Interessanter Ansatz, auch wenn die Gerichte erfahrungsgemäß der Wettbewerbszentrale eine Klagebefugnis zuerkennen.
Geklagt hat AEP wiederum schon selbst gegen Trümper. Der hatte nämlich geäußert, Apotheker könnten sich gemäß dem geplanten Anti-Korruptionsgesetz strafbar machen, wenn sie die AEP-Konditionen annehmen. Es wird noch gestritten.
Fakt ist, dass das Anti-Korruptionsgesetz noch in der Planung ist und Experten erheblichen Nachbesserungsbedarf am bisherigen Entwurf sehen. Vor allem die Verknüpfung mit dem Berufsrecht könnte unvorhersehbare Folgen haben, wenn Apothekerkammern plötzlich am Strafrecht mitschreiben dürften. Ob alle 17 Kammerpräsidenten mit dieser Machtfülle verantwortungsbewusst umzugehen wüssten? Vielleicht ist es gut, dass die gerade mehr mit Immobilienangelegenheiten beschäftigt sind.
Und damit wären wir bei Josef Hecken. Der Vorsitzende des Gemeinsamen Bundesausschuss (G-BA) macht seine Sache offenbar so gut, dass die gesetzliche vorgeschriebene Amtszeitbegrenzung gesetzgeberisch wieder aufgehoben werden voll. Neues geltendes Recht wird geschaffen.
Wohin das mit zu viel Macht führen kann, sieht man auch bei den Krankenkassen: Einige akzeptieren neuerdings anscheinend nachgereichte Großhandelsbelege zur Lieferfähigkeit nicht mehr. Wenn ein Rabattarzneimittel nicht verfügbar ist – was vorkommen soll –, müsse sich der Apotheker dies am gleichen Tag bestätigen lassen.
Zweiter Fall: Eine Ärztin bekommt einen Regress von 16.000 Euro aufgebrummt, weil sie die Apotheke nicht umging. Nach der Logik der Kasse und dem politisch nachgelagerten Bundessozialgericht (BSG) musste die Allgemeinmedizinerin das Bluterpräparat direkt beim Hersteller bestellen, weil sie es durfte.
Apropos beim Falschen bestellt: Der Reimporteur Eurim muss einzelne Chargen von Clexane und Spiriva zurückrufen: „Es kann nicht ausgeschlossen werden, dass einzelne Packungen der genannten Charge nicht verkehrsfähig sein könnten.“ Dabei hieß es früher doch noch, es müsse doppelt gut kontrolliert werden, sobald „quer eingekauft“ wird. Wirtschaftliche Vorteile dürfen keine Rolle spielen.
Wirtschaftliche Nachteile sehen Trümper und seine Freunde vom Großhandel, wenn sie die Temperatur in den Lieferautos ihrer Subunternehmer konstant halten sollen, die Versandapotheken ihre Päckchen aber jeder Witterung ausgesetzt mit der Post verschicken dürfen. Das Bundesgesundheitsministerium führt auf Nachfrage der Noweda aus, dass auch beim „Versandhandel sichergestellt werden muss, dass Qualität und Wirksamkeit erhalten bleiben muss“. Ungeprüft gilt dabei als sichergestellt.
Die Noweda streitet derzeit auch mit dem brandenburgischen Landesamt für Umwelt, Gesundheit und Verbraucherschutz. Das will der Genossenschaft verbieten, Arzneimittel aus Apotheken zurückzunehmen, wenn diese nicht zuvor auch nachweislich an die Apotheke geliefert wurden. Eine Kopie des Nachweises am besten gleich an die Krankenkasse schicken.
Zum Schluss doch noch einmal die ABDA. Die hat in dieser Woche ihr Sommerfest in der Heilig-Kreuz-Kirche in Kreuzberg gefeiert, zwei Umzüge und ein neues Haus beschlossen sowie einen internen Umbau und sich eine Haushaltserhöhung von 5 Prozent verordnet. Bis die Apotheker irgendwann auf der Matte stehen und sagen: „I want my money back!“

APOTHEKE ADHOC Debatte